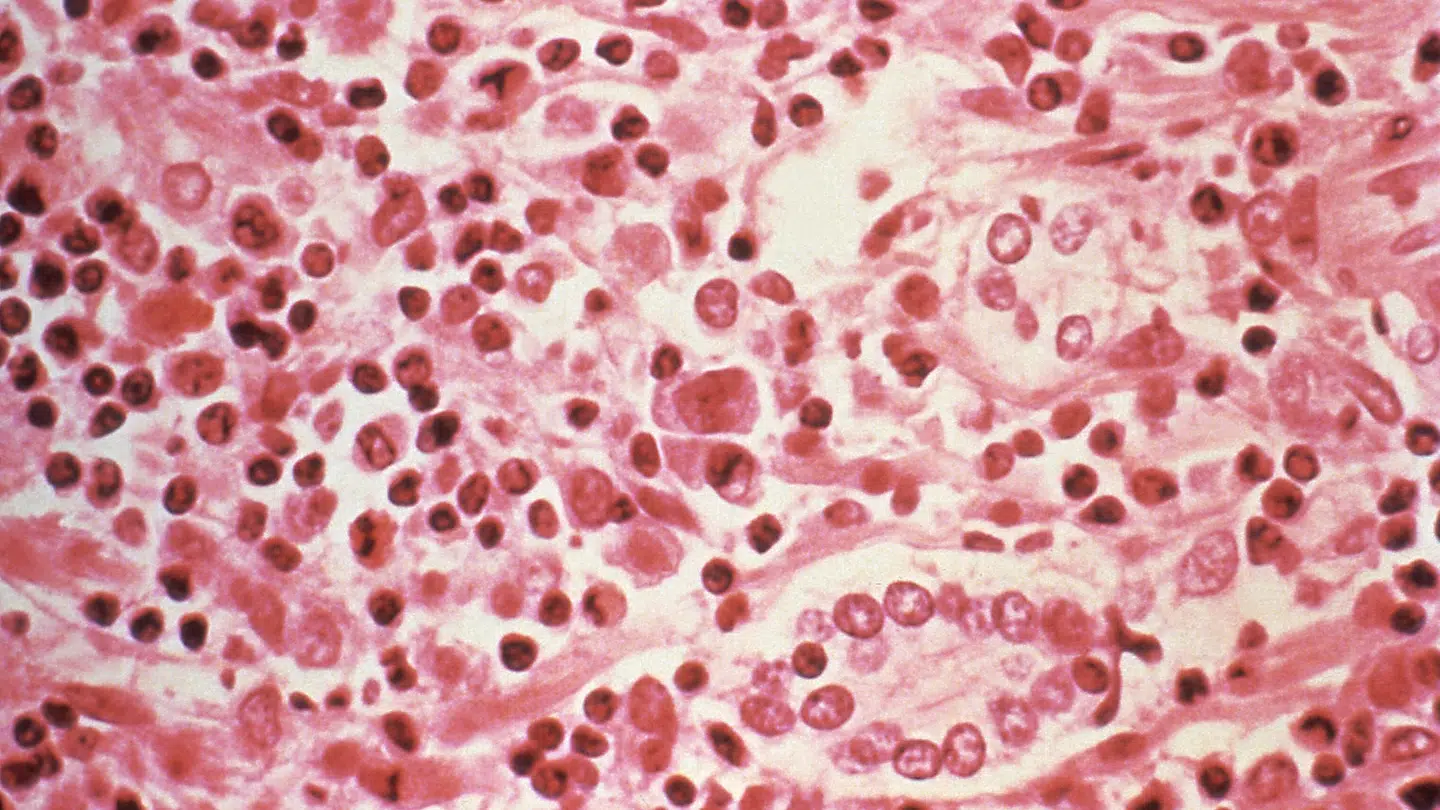
Der er blandt andet hantavirus i blandt de hætteglas, der er forsvundet.

Flere hundrede prøver med dødelig virus er forsvundet fra et laboratorium i Australien.
Det bekræfter regeringen i Queensland i en pressemeddelelse.
Faktisk var det helt tilbage i 2023, at de 323 hætteglas med smitsomme vira som Hendra-virus, Lyssa-virus og Hanta-virus forsvandt fra Queenslands Public Health Virology Laboratory.
Regeringen vil nu have igangsat en undersøgelse af det, de kalder for et »stort historisk brud på biosikkerhedsprotokollerne«.
»Med et så alvorligt brud på biosikkerhedsprotokollerne og potentielt manglende prøver af smitsom virus må Queensland Health undersøge, hvad der skete, og hvordan man kan forhindre, at det sker igen«, siger sundhedsminister Timothy Nicholls i pressemeddelelsen.
Ifølge Center for biosikring og bioberedskab er Hendra-virus er en zoonotisk virus, der kun er blevet fundet i Queensland og New South Wales i Australien.
Lyssavirus omfatter 17 virusarter samt to formodede virusarter, og den mest kendte er Rabies-virus, som har 100 procent dødelighed, når først der er symptomer.
Hantavirus dækker over en stor gruppe virus, der hver har en gnaver som vært. Mennesker kan smittes via bid, og dødeligheden er på mellem 35 og 40 procent.
Det vides endnu ikke, om de forsvundne prøver et blevet stjålet eller destrueret.